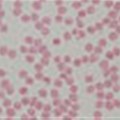
New therapies offer real hope in fight against cancer

Subscribe to daily business and company news across 19 industries
×News






Health & Social Welfare
Ster-Kinekor's CSI flagship initiative offers free eye screening to the public


Infectious Diseases
How The Gambia beat trachoma, an infection that causes blindness




Health & Social Welfare
Right to Sight Trust urgently needs funding in support of eyesight-saving surgery



Infectious Diseases
Ebola survivors can lose their eyesight. What we're doing to prevent it